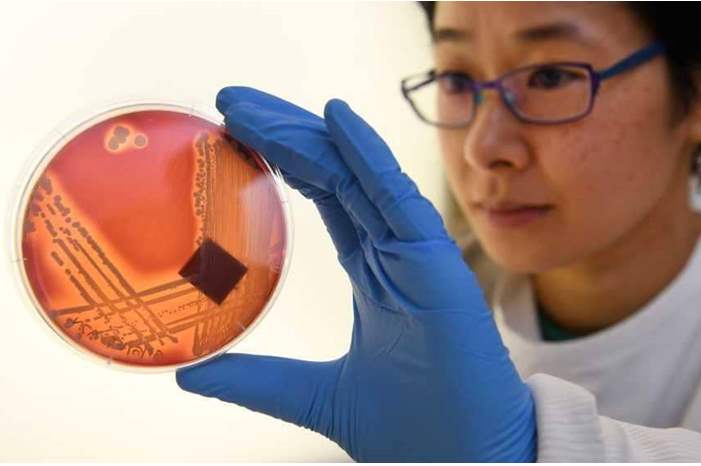
1-1193177

نبه تقرير طبي صدر حديثا، إلى أن أنواعا خطيرة من البكتيريا ستحصد أرواح الملايين من الأشخاص بحلول العام 2050، إذا لم يجد الطب حلا لأزمة المضادات الحيوية التي تفقد نجاعتها أكثر فأكثر.
وبحسب ما نقلت صحيفة "ديلي ميل" البريطانية، فإن بعض الاضطرابات الصحية البسيطة في أيامنا هذه ستصبح مميتة في المستقبل، إذا فقدت المسكنات والمضادات الحيوية نجاعتها.
وترجح تقديرات أن مقاومة المضادات الحيوية تؤدي إلى 5 آلاف حالة وفاة سنويا في بريطانيا، إلى جانب 25 ألف في بلدان الاتحاد الأوروبي، ومن المحتمل أن يصل هذا الرقم إلى عشرة ملايين خلال السنوات الثلاثين المقبلة، مع توقعات بتسجيل وفيات كارثية حول العالم أيضا.
اظهار أخبار متعلقة
وأورد تقرير أعدته لجنة الرعاية الصحية والاجتماعية في مجلس العموم البريطاني، أن الحكومة لم تقم بجهد كاف لمعالجة هذه الأزمة بالرغم من طابعها الملح.
ويقول متابعون إن شركات صناعة الأدوية لم تصنع جيلا جديدا من المضادات الحيوية، لأنها لا ترى أرباحا كبيرة في هذا الجانب، ولذلك فإن البشرية في حاجة إلى من يموّل مثل هذه التجارب الطبية.
ويحتاج مرضى السرطان مثلا إلى أدوية مضادة للبكتيريا حتى يضمنوا حماية أجسامهم بسبب ما يتعرض له الجهاز المناعي من إضعاف أثناء الخضوع لعلاج كيميائي، لكن هذا قد لا يتم بنجاح، إذا أصبحت بعض أنواع البكتيريا مستعصية على العلاج بالمضادات.